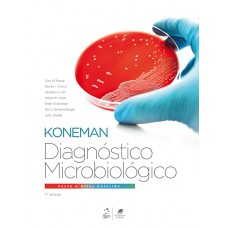
Diagnóstico Microbiológico - Texto e Atlas Colorido

Medicina
Dicionário de epônimos
A motivação para este trabalho foi a ausência de qualquer literatura em português que facilitasse a ..
R$42,00
Vendido e entregue por Fidelivros - Manaus
Dicionário brasileiro de nutrologia
Dicionário Brasileiro de Nutrologia é lançado no melhor momento possível, ao se considerar a carênci..
R$100,00
Vendido e entregue por Fidelivros - Manaus
Diálogos sobre a boca
''Diálogos sobre a Boca'''' não se destina apenas a cirurgiães-dentistas ou a profissionais clínicos..
R$78,00
Vendido e entregue por Fidelivros - Manaus
Diálogos Interdisciplinares Em Saúde Coleção Diálogos Interdisciplinares Em Saúde - Volume 2
A coletânea Diálogos Interdisciplinares em Saúde (Volume 2) reúne estudos interdisciplinares em dive..
R$61,80
Vendido e entregue por Fidelivros - Manaus
Diagnósticos de Enfermagem
Esta nova edição do respeitado Diagnósticos de enfermagem continua oferecendo ao leitor informações ..
R$266,00
Vendido e entregue por Fidelivros - Manaus
Diagnóstico por ultrassom: cabeça e pescoço
Diagnóstico por Ultrassom: Cabeça e Pescoço é uma obra de referênciaindispensável para o Radiologist..
R$817,00
Vendido e entregue por Fidelivros - Manaus
Diagnóstico por imagem para otorrinolaringologistas
Projetado por um renomado otorrinolaringologista, revisado e complementado por radiologistas experie..
R$368,00
Vendido e entregue por Fidelivros - Manaus
Diagnóstico por imagem em ortopedia
A evolução contínua dos métodos de diagnóstico por imagem torna o campo da radiologia instigante pel..
R$183,00
Vendido e entregue por Fidelivros - Manaus
Diagnóstico por imagem das doenças do tórax
O conteúdo desta obra, extremamente prática, didática e objetiva, permite ao residente e ao radiolog..
R$1.398,00
Vendido e entregue por Fidelivros - Manaus
Diagnóstico por Imagem da Face
Com a proposta pioneira de demonstrar como realmente as técnicas de imagens volumétricas podem contr..
R$432,00
Vendido e entregue por Fidelivros - Manaus
Diagnóstico por imagem - musculoesquelético
Esta edição de Diagnóstico por Imagem - Musculoesquelético - Doenças não Traumáticas, de Manaster, c..
R$2.611,00
Vendido e entregue por Fidelivros - Manaus
Diagnóstico por imagem - Encéfalo
Mais de 300 diagnósticos delineados, referenciados e ricamente ilustrados destacam a 3ª edição deste..
R$1.378,00
Vendido e entregue por Fidelivros - Manaus
Diagnóstico por imagem
Nesta obra, os autores vão ao encontro das necessidades do estudante de medicina e do médico, por me..
R$601,00
Vendido e entregue por Fidelivros - Manaus
Diagnóstico por Imagem
Diagnostico por imagem: cabeca e pescoco vai direto ao ponto, pois apresenta, para cada doenca, as i..
R$146,00
Vendido e entregue por Fidelivros - Manaus
Diagnóstico Microbiológico - Texto e Atlas Colorido
Diagnóstico Microbiológico | Texto e Atlas é uma fonte abrangente e de fácil compreensão, que propor..
R$1.114,00
Vendido e entregue por Fidelivros - Manaus
Diagnóstico Laboratorial das Principais Doenças Infecciosas e Autoimunes
Nos últimos anos, a incorporação de laboratórios de pequeno e de médio porte a grandes redes tem pos..
R$446,00
Vendido e entregue por Fidelivros - Manaus